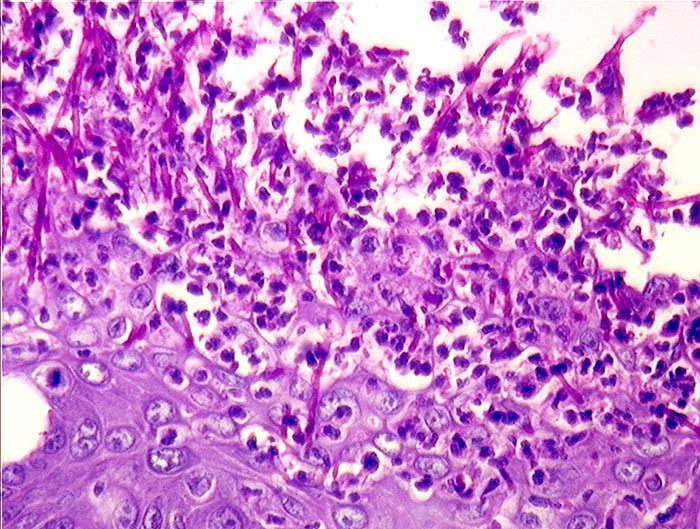

PathoPic – image database / PathoPic ID 1463 - Soorösophagitis
de
Diagnose
Soorösophagitis
Diagnose Gruppe
Entzündung infektiös
Topographie
Oesophagus
Topographie Gruppe
Oesophagus, Magen
Beschreibung
Granulozytäres Entzündungsinfiltrat und Soor-Pseudohyphen erodieren die Schleimhautoberfläche.
Zusatzbefund
Soorstomatitis. Aortenbioprothese.
Kommentar
Bilder Typ
Histologie
Alter
69
Geschlecht
männlich
Datum
Ersteintrag: 17.12.2000